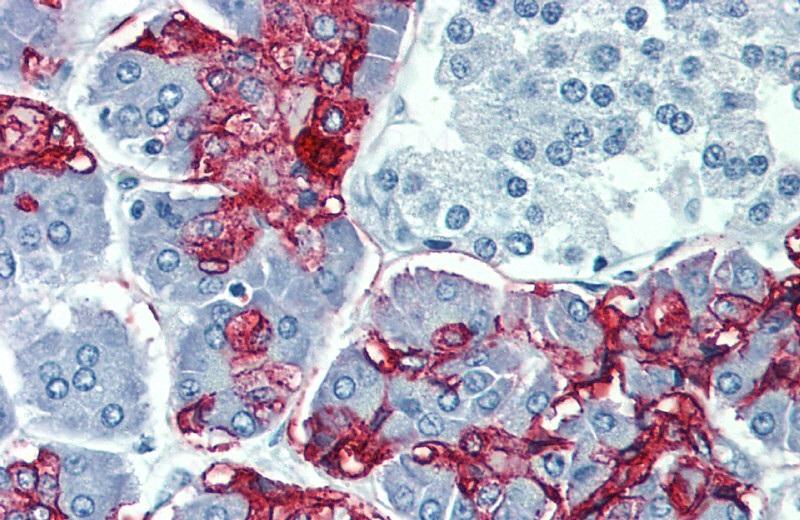

Anti-Blood Group Lewis a Monoclonal Antibody (Clone:7LE)
Figure 1: Immunohistochemistry staining of colorectal adenocarcinoma (paraffin-embedded sections) with anti-human Blood Group Lewis a (7LE).
Roll over image to zoom in
Shipping Info:
For estimated delivery dates, please contact us at [email protected]
Format : | Purified |
Amount : | 0.1 mg |
Isotype : | Mouse IgG1 |
Purification : | Purified by protein-A affinity chromatography |
Storage condition : | Store at 2-8°C. Do not freeze. |
Immunohistochemistry Recommended dilution:5 µg/ml
Positive control:colorectal adenocarcinoma
For Research Use Only. Not for use in diagnostic/therapeutics procedures.
Subcellular location: | Golgi apparatus |
Tissue Specificity: | Highly expressed in stomach, colon, small intestine, lung and kidney and to a lesser extent in salivary gland, bladder, uterus and liver. |
BioGrid: | 108801. 20 interactions. |
There are currently no product reviews
|